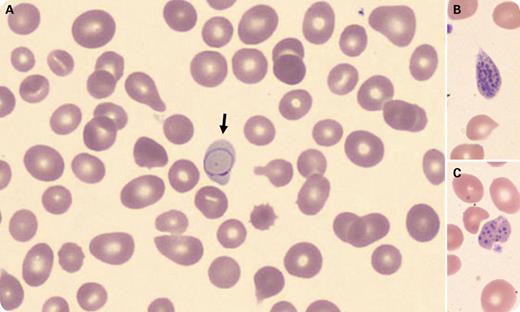
A 12-year-old female presented with fatigue and weight loss. She appeared pale and had gray streaks in her hair. She had a history of chronic anemia, and some family members also had anemia. Laboratory tests showed macrocytic anemia (hemoglobin 5.2 g/dL, MCV 107.3 fL) and thrombocytopenia (platelet count 129 × 109/L), increased blood homocysteine (111.6 μmol/L, reference range 4.7-10.3), and decreased vitamin B12 (111 pg/mL, reference range 260-935). Wright-stained peripheral blood smear showed macrocytosis, anisopoikilocytosis, a few polychromatophilic red blood cells with rare purple Cabot rings (panel A, arrow), and coarse basophilic stripling (panels B and C). Workup for vitamin B12 deficiency identified a homozygous pathogenic variant in the AMN gene, which is consistent with Imerslund-Gräsbeck syndrome (IGS), a rare autosomal recessive disorder caused by a defect in the receptor of vitamin B12–intrinsic factor complex in terminal ileum. This receptor is composed of 2 proteins, amnionless (AMN) and cubilin (CUBN). Mutations of either the AMN or CUBN gene can cause IGS. / Cabot rings are thin, threadlike ring- or “figure eight”–shaped red blood cell inclusions, likely remnants from mitotic spindles. They are rarely seen in peripheral blood, and their presence indicates a defect in erythrocyte production, especially in pernicious anemia and lead poisoning.

A 12-year-old female presented with fatigue and weight loss. She appeared pale and had gray streaks in her hair. She had a history of chronic anemia, and some family members also had anemia. Laboratory tests showed macrocytic anemia (hemoglobin 5.2 g/dL, MCV 107.3 fL) and thrombocytopenia (platelet count 129 × 109/L), increased blood homocysteine (111.6 μmol/L, reference range 4.7-10.3), and decreased vitamin B12 (111 pg/mL, reference range 260-935). Wright-stained peripheral blood smear showed macrocytosis, anisopoikilocytosis, a few polychromatophilic red blood cells with rare purple Cabot rings (panel A, arrow), and coarse basophilic stripling (panels B and C). Workup for vitamin B12 deficiency identified a homozygous pathogenic variant in the AMN gene, which is consistent with Imerslund-Gräsbeck syndrome (IGS), a rare autosomal recessive disorder caused by a defect in the receptor of vitamin B12–intrinsic factor complex in terminal ileum. This receptor is composed of 2 proteins, amnionless (AMN) and cubilin (CUBN). Mutations of either the AMN or CUBN gene can cause IGS.
Cabot rings are thin, threadlike ring- or “figure eight”–shaped red blood cell inclusions, likely remnants from mitotic spindles. They are rarely seen in peripheral blood, and their presence indicates a defect in erythrocyte production, especially in pernicious anemia and lead poisoning.
A 12-year-old female presented with fatigue and weight loss. She appeared pale and had gray streaks in her hair. She had a history of chronic anemia, and some family members also had anemia. Laboratory tests showed macrocytic anemia (hemoglobin 5.2 g/dL, MCV 107.3 fL) and thrombocytopenia (platelet count 129 × 109/L), increased blood homocysteine (111.6 μmol/L, reference range 4.7-10.3), and decreased vitamin B12 (111 pg/mL, reference range 260-935). Wright-stained peripheral blood smear showed macrocytosis, anisopoikilocytosis, a few polychromatophilic red blood cells with rare purple Cabot rings (panel A, arrow), and coarse basophilic stripling (panels B and C). Workup for vitamin B12 deficiency identified a homozygous pathogenic variant in the AMN gene, which is consistent with Imerslund-Gräsbeck syndrome (IGS), a rare autosomal recessive disorder caused by a defect in the receptor of vitamin B12–intrinsic factor complex in terminal ileum. This receptor is composed of 2 proteins, amnionless (AMN) and cubilin (CUBN). Mutations of either the AMN or CUBN gene can cause IGS.
Cabot rings are thin, threadlike ring- or “figure eight”–shaped red blood cell inclusions, likely remnants from mitotic spindles. They are rarely seen in peripheral blood, and their presence indicates a defect in erythrocyte production, especially in pernicious anemia and lead poisoning.
For additional images, visit the ASH Image Bank, a reference and teaching tool that is continually updated with new atlas and case study images. For more information, visit http://imagebank.hematology.org.
This feature is available to Subscribers Only
Sign In or Create an Account Close Modal